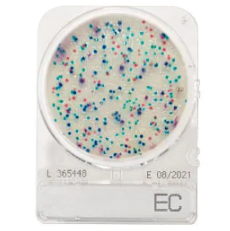
CompactDry™ EC (E. coli and coliforms)
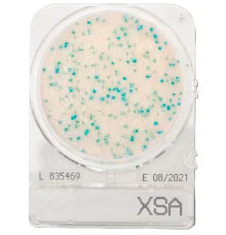
CompactDry™ X-SA for Staphylococcus aureus

Kosár0
Ár kérése
A kromogén táptalajok a mikrobiológiában használt speciális táptalajok, amelyek a mikroorganizmusok azonosítására szolgálnak a képződött telepek színe alapján. A szín a táptalajban lévő anyagokból származik, amelyek kölcsönhatásba lépnek az azonosítandó mikroorganizmus(ok) specifikus anyagcsereútjaival.
A CompactDry egy használatra kész módszer, amely csökkenti a mikrobiális elemzési időt és javítja a minőségellenőrzési folyamatokat. A CompactDry® dehidratált, szelektív és kromogén táptalajok az össz-mikrobiális szám és/vagy a mikrobiális fajok azonosítására. Alkalmazási területei a nyersanyagok, élelmiszerek, italok, kozmetikumok szabályozása, valamint a környezeti levegő és/vagy felületek monitorozása.
| Típus | Leírás |
|---|---|
| Compact Dry® AQ | A lemez tápanyagban szegény táptalajt tartalmaz a heterotróf organizmusok telepszámának meghatározására kezelt ivóvízben és ultratiszta vízben. |
| Compact Dry® CF (Coliforms) | Koliformok kimutatására szolgáló táptalaj |
| CompactDry™ EC (E. coli and coliforms) | A CompactDry™ EC egy táptalaj az E. coli és a coliform baktériumok kimutatására. A táptalaj két különböző kromogén enzim szubsztrátot tartalmaz: Magenta-Gal és X-Gluc. |
| CompactDry™ ETB for Enterobacteriacae | A CompactDry™ ETB egy nagyon könnyen használható rendszer az Enterobacteriacae kimutatására. Szubsztrátjai lehetővé teszik az Enterobacteriacae megkülönböztetését más csoportoktól. |
| Compact Dry® ETC (Enterococos) | Kromogén táptalaj az Enterococos kimutatására. |
| CompactDry™ LS for Listeria species | A CompactDry™ LS-t a Listeria mennyiségi kimutatására használják élelmiszerekben és italokban. Felületek és munkakörnyezetek értékelése a CompactDry™ mintavevő segítségével. |
| CompactDry™ PA for Pseudomonas aeruginosa | CompactDry™ PA a Pseudomonas aeruginosa mennyiségi kimutatására. |
| Compact Dry® SL (Salmonella) | Salmonella kimutatási táptalaj, 20-24 órával a dúsítás előtt, elődúsítási táptalajokban. |
| CompactDry™ TC (Total Count) | A CompactDry™ TC egy táptalaj az összes életképes baktériumszám meghatározásához, amely tápanyag-standard agart tartalmaz. |
| Compact Dry® VP (Vibrio parahaemolyticus) | V. parahaemolyticus kimutatási táptalaj, amely lehetővé teszi a megkülönböztetését más vibrióktól, a szervezet számára kromogén szubsztrát jelenlétének köszönhetően. |
| Compact Dry® X-BC (Bacillus cereus) | Bacillus cereus kimutatási táptalaj. |
| CompactDry™ X-SA for Staphylococcus aureus | A CompactDry™ X-SA egy táptalaj, amelyet a Staphylococcus aureus szelektív növekedés és differenciálás útján történő meghatározására használnak. |
| CompactDry™ YM for yeast and mould | A CompactDry™ YM a jellegzetes színfejlődés és morfológia alapján különbözteti meg az élesztő- és penészgombákat. A CompactDry™ YM nagyon jó 3 dimenziós növekedést tesz lehetővé az élesztő- és penészgombák számára. |
| Compact Dry® YMR rapid (moulds and yeasts) | Penész- és élesztőgombák kimutatására szolgáló közeg |
Belépés / Regisztráció